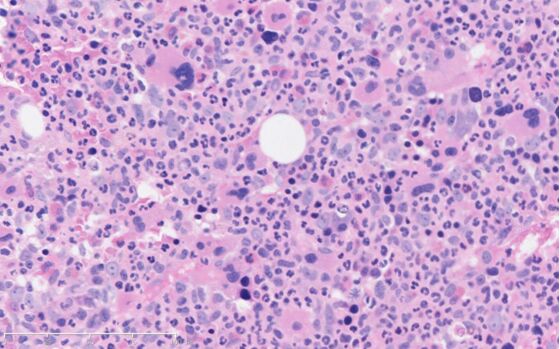
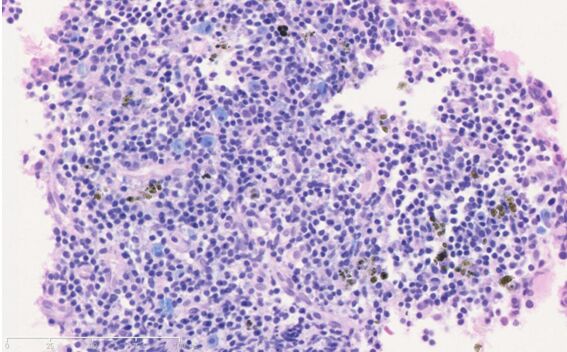

HE-天青II双染法在骨髓穿刺活检石蜡切片染色中的应用
HE-天青II双染法在骨髓穿刺活检石蜡切片染色中的应用
王华 夏朝霞 施婧婧
宁波市临床病理诊断中心
[摘要] 目的:探索一种操作简便,能够更为清晰的显示骨髓穿刺石蜡组织切片中不同发育阶段的三系细胞的染色方法。方法:选取120例骨髓病理活检石蜡包埋组织,分别行HE染色和天青II-HE染色,对骨髓切片中各系细胞染色的效果进行判读,比较和评价HE-天青II双染法与常规HE染色在骨髓穿刺石蜡组织切片的染色效果。结果:天青II-HE染色法比HE染色更加清晰的显示出骨髓穿刺石蜡组织切片中不同发育阶段的红系、粒系、巨核系骨髓细胞的胞浆嗜碱性。天青II-HE染色法可以显示出HE染色不能显示的嗜碱性粒细胞。结论: 在骨髓穿刺石蜡组织切片染色中,天青II-HE染色法操作简便,可以作为骨髓活检常规HE染色的补充,为骨髓活检病理诊断提供更多技术手段。
[关键词]骨髓穿刺,病理活检,石蜡切片;HE染色;HE-天青II染色;
骨髓病理学诊断即骨髓活组织诊断(bone marrow biopsy,BMB),简称骨髓活检,以病理组织切片为标本,进行的骨髓组织(造血组织和细胞)形态学检验和分析评估【1】。优良的骨髓穿刺活检石蜡切片染色技术是骨髓活检病理诊断的基础,也是病理技术工作中的难点。传统常规HE染色方法是骨髓穿刺活检的基础染色方法,但HE染色在显示不同分化发育阶段的红系、粒系骨髓细胞胞浆的嗜碱性差异和嗜碱性粒细胞的嗜碱性颗粒等方面都不理想。探索一种新的染色方法,能有效的显示不同种类及不同发育阶段的骨髓细胞的形态特点,将对骨髓穿刺活检病理诊断的准确性提供有效的帮助。
1 材料和方法
1.1 材料选择宁波市临床病理诊断中心骨髓穿刺活检石蜡包埋标本120例。
1.2主要仪器 ThermoMICROMHm325切片机。
1.3试剂 GS环保HE染色套装,天青II染液。
2 方法
2.1 骨髓活检组织前处理骨髓穿刺组织经中性缓冲福尔马林固定12小时骨髓脱钙液脱钙后,常规脱水、包埋。
2.2切片 骨髓穿刺活检石蜡包埋组织切片厚度2μm,连续切片2张。
2.3 HE染色 采用GS环保HE染色套装进行手工染色。
2.4 HE-天青II染色 根据骨髓HE切片的情况选择含三系骨髓细胞超过40%骨髓穿刺活检组织切片进行HE-天青II双染。染色步骤:①GS环保脱蜡剂切片脱蜡至水,②苏木素染色5min,③水洗1min,④0.1%盐酸乙醇分化至细胞核清晰胞浆无明显苏木素非特异性染色,⑤饱和碳酸锂水溶液返兰3s,自来水洗5min,⑥天青II染液浸染5min,蒸馏水洗5min,⑦0.01%醇溶性伊红浸染5min⑧梯度酒精脱水,⑨GS环保透明剂透明,⑩环保封片胶封片
3结果
骨髓穿刺组织HE切片120例,其中含三系骨髓细胞超过40%的病例78张进行HE-天青II染色。HE-天青II染色切片中各系骨髓细胞形态完整,核膜核仁清晰,核浆对比清晰,不同发育阶段的红系、粒系、巨核系胞浆嗜碱性差异明显,粒系细胞胞浆的嗜酸性颗粒、嗜碱颗粒清晰,对比明显 (图A、B)。78例HE-天青II染色切片中观察到嗜碱性粒细胞的5例(6.4%)。相同病例对应的HE染色各系骨髓细胞形态完整,核膜核仁清晰,核浆对比清晰,嗜酸性粒细胞胞浆颗粒清晰,但胞浆嗜碱性弱,不同发育阶段的骨髓细胞胞浆嗜碱性差异不明显。78例HE染色切片中观察到嗜碱性粒细胞的0例(0%)。其中一例骨髓HE-天青II染色切片中局部显示有较多嗜碱性粒细胞,在HE染色切片相同区域中未观察到嗜碱性粒细胞的存在,与嗜碱性粒细胞形态特点相似的细胞胞浆颗粒显示具有嗜酸性(图C、D)。
4 讨论
骨髓活检石蜡包埋切片染色技术的质量是准确进行骨髓病理诊断的基础。骨髓细胞中的红系、粒系、巨核系三系细胞越幼稚,胞质染色越深(嗜碱),细胞越成熟,染色越浅淡(嗜酸);以胞浆染色深浅判断有核红细胞、粒细胞、和巨核细胞的成熟度【2】。常规HE切片染色中红系、粒系、巨核系不同发育阶段的骨髓细胞胞浆嗜碱性差异小,不能区分嗜酸性颗粒与嗜碱性颗粒,造成骨髓病理诊断的困难。
天青II染料系亚甲蓝与天青I的等量混合物,而天青I主要由天青A、天青B的混合物,亚甲蓝(C16H18ClN3S·3H20),天青A(C14H14ClN3S)、天青B(C15H16ClN3S)三种染料均溶于水,水溶液中三种染料分子电离而带正电,能够与骨髓细胞胞浆中的嗜天青分子成分有特异的结合。不同发育阶段的骨髓细胞胞浆中所含的嗜天青颗粒成分有明显差异,天青II染料分子的对胞浆嗜碱性成分的结合使其呈现出不同程度的嗜碱性。使骨髓细胞中的不同发育阶段的骨髓细胞更易于区分。天青II染料在水溶液中呈正电,染色过程中对组织与细胞中嗜伊红的组织成分影响小,使用HE-天青II双染法在HE染色的基础上增加了天青II染液的染色特点,弥补了常规HE染色不能显示的嗜天青成分,胞核红蓝对比更鲜明,处于不同发育阶段的三系骨髓细胞胞浆嗜碱性有层次。HE-天青II双染法操作简便,是一种可以推广的骨髓活检石蜡组织切片染色新方法。
参考文献:
【1】卢兴国.骨髓细胞学和病理学.北京:科学出版社,2008:3-5.
【2】陈辉树.骨髓病理学.北京:人民军医出版社,2010:25-26

图A:病例一(HE-天青II染色)
图B:病例一(HE染色)
图C:病例二(HE-天青II染色)显示嗜碱性粒细胞

图D:病例二(HE染色)在HE-天青II染色中胞浆嗜碱性颗粒在HE染色中显示为嗜酸性
下载地址:/uploadfile/file/20170811/20170811163945_36119.doc

 登陆会员
登陆会员 注册会员
注册会员


 下载中心
下载中心
 病理论坛在线咨询
病理论坛在线咨询